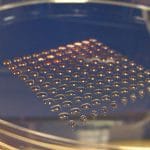
3d printing healthcare applications

Recently, we have observed Dubai working to implement several advancements, which are seemingly the next local steps. A coffee company delivered beverages to several beachgoers on the local beach; Nokia tested their air traffic management system in the city and Dubai’s Crown Prince Sheikh Hamdan bin Mohamed rode on a passenger drone with an aim of showing faith and support. However, the most recent announcement from the government of Dubai and Dubai Police might be hard to believe and somewhat dystopian. The Dubai Police has planned to add flying Electric Police Hoverbikes to their law enforcing officers’ fleet.
Announced at GITEX, the largest technology expo within the region, the electric police hoverbike relies on electric power to function and can travel for 43 miles per hour with the pilot on board. New Atlas reported that the hoverbike could fly up to 16 feet as the maximum altitude. Unmanned, the electric drone can reach a speed close to 62mph. And regarding its flight times, to run for around 20-25 minutes the drone requires at least three hours of charge. Fortunately, the pilot can easily swap its batteries out therefore foregoing possible charge-related pitstops.
Most people believe that the plan is more of public relations. Police officers using hoverbikes to chase suspects down the streets is futuristic for the year 2017. Actually, traditional high-speed automobiles are far more efficient and familiar in helping the police accomplish their high-octane work. It is seemingly ludicrous to engage police squadron riding the largely unsafe drones through Dubai endangering the civilians around them. The electric hoverbikes are also unlikely to increase efficiency of the law enforcement agency. Put differently, how will the hoverbikes help police officers do their work?
Who will supply the drones?
The expected Electric Police Hoverbikes have their base on the Russian Hoversurf Scorpion 3 drones, which were unveiled earlier in the year 2017. The Dubai Police will first concentrate on further testing before creating a real drone division to utilise the hoverbikes in both unmanned and manned police work.
History of Hoverbikes
People from health and safety departments might never get close to the electric police hoverbikes in Dubai. However, aspiring amputees might desire to ride one. The hoverbikes are motorbike styled and have four high-speed propellers that the manufacturer mounts right at a leg-amputation level. Even more, the hoverbikes will fly high enough to strike the pilot violently on rafters.
Creation of multi-rotor drones meant that we would soon witness manned self-stabilizing airframes carrying people around the city. The first drones offered vertical take offs and the hovering advantages of helicopters without mechanical complexities, difficult four-limbed control schemes, high maintenance costs or the large noisy top rotors.
It was not obvious that it would be easy to build the manned drones. Now, we have started observing large lithium-ion battery packs and strong responsive electric motors sold off the shelf. Inertial measurement units, accelerometers and GPS chips are incredibly plentiful and cheap. Flight control software and hardware has matured relatively fast within the last few years.
Some aviation companies are using a new generation of electric VTOL aircraft development to get on board, but some irregular inventors are also making the things in their backyards and factory spaces. And where large aviation companies are taking safety-first risk moderation, the guys are using themselves as the guinea pigs. They run unmanned drone tests on drones, they then proceed to hop on board, and they then try several tethered flights and finally set up video cameras. After that, they are able to jump on board and take to the skies. Some of the videos they have produced are awesome but terrifying to watch.
Why the electronic police hoverbikes might not be safe
The electronic police hoverbikes use four props. That fundamentally leaves zero redundancy if the motor or the electronic stability controls (ESC) failed. In fact, such failure would see the manned drone flip over and fall from the sky. The large props respond to stabilization inputs slowly than the smaller units therefore potentially making for keel rides whenever the machine encounters windy skies.
The damn props are also very close to the rider’s legs. The fragile protective barriers lie between huge fast rotating propellers and soft legs. At least, they are seemingly wooden – not lightweight carbon, which has a tendency of shattering rather than deforming.
Passenger drones in Dubai
Earlier, Dubai announced its plan to introduce passenger drones that will transport passengers without the need of a pilot. The head of Roads and Transportation Agency Mattar al-Tayer announced the arrival of the drone at the World Government Summit. The drone will possibly be the first vehicle of its kind in the city. Before the announcement, the drone had its flying debut over Burj al-Arab skyscraper hotel.
The passenger drone can ferry one passenger – with a weight less than 100 kilograms – at a time and can remain in air for at least 30 minutes on a single charge. When inside, the passenger uses a touchscreen to choose the destination and then the command centre auto-pilots it.
The drone has no passenger override function. In other words, anyone can board it without the need of a pilot’s license. The manufacturer designed it in a unique way to ensure that it can complete its flights even after one propeller has failed. The Ehangen fail-safe system enables the drone to land immediately on the closest available area. Designer Paul Priestman had announced that personal flying machines would support the future transportation systems. People are already flying drones everywhere.
The future of Electric Police Hoverbikes
By now, most drone enthusiasts are happy that manned drones do exist. The futuristic science-fiction-based machines that most people could only dream of in the 1980s now exist. However, the tech has to be applied logically, practically and safely. The Government of Dubai should not expect the crime rate to drop after it has introduced the manned drones in the police department.
Fortunately, the Dubai Police has announced that they will conduct more testing before incorporating the air vehicles like Electric Police Hoverbikes in their law enforcement fleet. We have seen application of drones in medical supply transportation and real estate video taking. We are waiting to see that in law enforcement agencies.